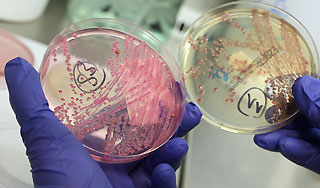

10 октября, четверг | ![]() ![]() ![]() |
![]() | ПОЛИТИКА | ЭКОНОМИКА | ОБЩЕСТВО | ПРОИСШЕСТВИЯ | КУЛЬТУРА | СПОРТ | МЕДИА | В МИРЕ | АВТО | ТЕХНОЛОГИИ | ![]() |
| Фоторепортажи | Видеосюжеты | Комментарии | Погода | Работа | Форум | Карта | Подписка и RSS | Реклама| О газете |
По миру ходит новый смертельный вирус15 июля 2011, пятница, 16:27 – БРЯНСК.RU | Комментарии: 0
| Версия для печати Новый смертельно опасный вирус, который может передаваться человеку, обнаружен у обезьян. Он вызывает пневмонию и гепатит. Один из сотрудников, лечивших больных животных, заразился вместе со своей семьей.В мае 2009 года в калифорнийском Национальном центре изучения приматов среди южноамериканских обезьян – красных прыгунов – произошла вспышка скоротечной пневмонии, сопровождавшейся гепатитом. Этому заболеванию подверглись 23 обезьяны из 65. И 19 из них, несмотря на лечение, умерли или были усыплены. При этом произошло заражение одного из сотрудников центра и членов его семьи. Как установили ученые из Калифорнийского университета, вспышку вызвал ранее неизвестный аденовирус, получивший обозначение TMAdV (titi monkey adenovirus), – один из типов ДНК-вирусов, которые могут поражать многих позвоночных, включая приматов и людей. Ранее считалось, что аденовирусная инфекция является специфичной для каждого вида. Человеческие аденовирусы не размножаются в клетках обезьян без специальных вирусов-помощников и не заражают грызунов, и наоборот. Однако на сей раз вирус перешел видовую границу. Последнее исследование показало, что заболевший острым респираторным заболеванием сотрудник центра, находившийся в близком контакте с зараженными обезьянами, заразился именно вирусом TMAdV. Им же заразились члены семьи ученого, не контактировавшие с обезьянами. Новый вирус оказался потенциально более опасным, чем, к примеру, вирус птичьего гриппа, который способен заражать людей, однако передаваться от человека к человеку уже не может. Как выяснилось, TMAdV способен распространяться и среди людей. "Открытие TMAdV, аденовируса, способного заражать и человека, и обезьян, свидетельствует, что необходим мониторинг аденовирусов как потенциальных источников межвидовых вспышек болезней", – отмечается в статье американских ученых. Вместе с тем исследователи полагают, что нет причин опасаться пандемии TMAdV, как в случае с другими вирусами, перешедшими видовую границу, сообщает РИА Новости. "Вирус перешел в человеческую популяцию достаточно давно и с тех пор циркулирует на достаточно низком уровне", – говорится в исследовании ученых. Источник:
|
![]() | ПОЛИТИКА | ЭКОНОМИКА | ОБЩЕСТВО | ПРОИСШЕСТВИЯ | КУЛЬТУРА | СПОРТ | МЕДИА | В МИРЕ | АВТО | ТЕХНОЛОГИИ | ![]() |
| Фоторепортажи | Видеосюжеты | Комментарии | Погода | Работа | Форум | Карта | Подписка и RSS | Реклама| О газете |
| Размещение рекламы в газете БРЯНСК.RU: Прайс-лист, тел. (4832) 37-19-38, почта info@briansk.ru Для информационных писем в редакцию: news@briansk.ru | ![]() | ![]() | ||
| 2005–2015 © Ежедневная интернет-газета БРЯНСК.RU При цитировании активная ссылка на БРЯНСК.RU обязательна Материалы газеты могут содержать информацию 18+ | ![]() | Открыв данный сайт, Вы соглашаетесь с Правилами cайта (договор-оферта). Если вы не согласны с Правилами, немедленно покиньте сайт! | ![]() |

В глубине экрана: Мастер-класс по ремонту телевизоров
Погружение в мир футбола онлайн: для поклонников Игры
Займ без проверок
Тотализаторы: что это такое и чем они отличаются от обычных ставок?
Играть в бесплатные игровые автоматы в онлайн-клубе Вулкан
Стоит ли посещать офтальмолога при замене очков?
Успешные игроки предпочитают игровые автоматы Вулкан
Новое казино Супер Слотс поможет воплотить ваши мечты в реальность







ПОПУЛЯРНЫЕ МАТЕРИАЛЫ










